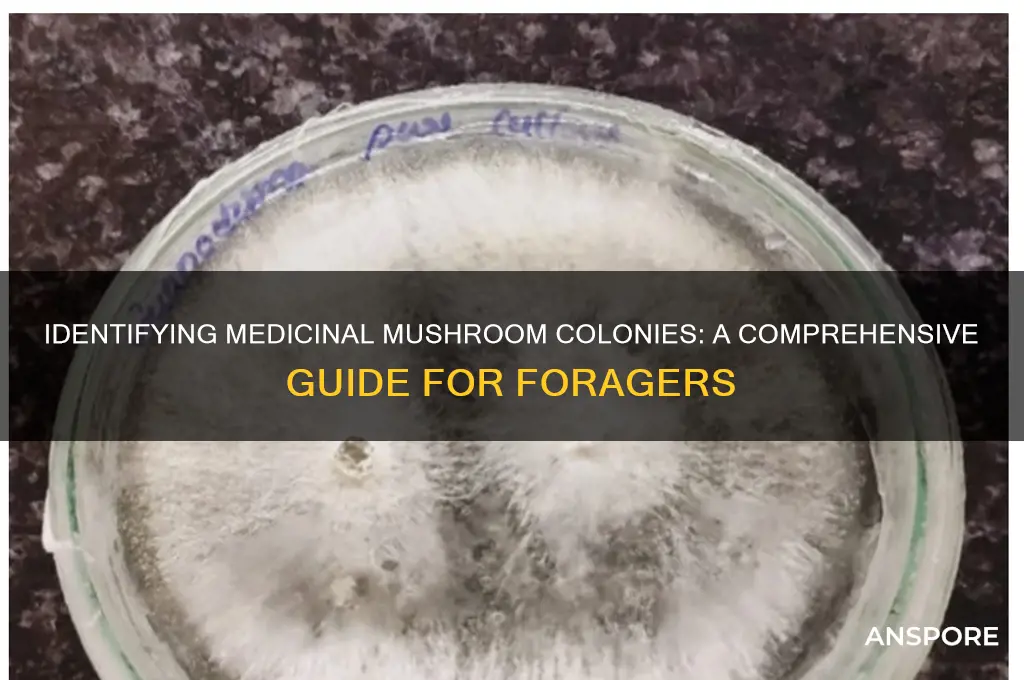
how to identify medicinal colonies for mushrooms

Identifying medicinal mushroom colonies requires a keen eye for detail and an understanding of their unique characteristics. These colonies often thrive in specific environments, such as decaying wood, soil rich in organic matter, or symbiotically with certain trees. Key features to look for include the mushroom's cap shape, color, and texture, as well as the presence of gills, pores, or spines underneath. Medicinal species like *Reishi* (Ganoderma lucidum), *Chaga* (Inonotus obliquus), and *Lion's Mane* (Hericium erinaceus) have distinct appearances: Reishi has a glossy, kidney-shaped cap with a woody texture, Chaga appears as a black, charcoal-like mass on birch trees, and Lion's Mane features cascading, icicle-like spines. Additionally, habitat and seasonality play crucial roles, as many medicinal mushrooms are found in temperate forests during late summer to fall. Always consult a field guide or expert to ensure accurate identification, as misidentification can lead to harmful consequences.
Explore related products
$19 $34.95
What You'll Learn
- Visual Characteristics: Examine color, shape, gills, cap texture, and stem features for identification
- Habitat Analysis: Study soil, climate, and surrounding plants where medicinal mushrooms grow
- Spore Print Testing: Collect and analyze spore colors to differentiate species accurately
- Smell and Taste: Note unique aromas and flavors associated with medicinal varieties
- Microscopic Examination: Use microscopy to identify cellular structures and confirm species

Visual Characteristics: Examine color, shape, gills, cap texture, and stem features for identification
When identifying medicinal mushroom colonies, visual characteristics are your first and most accessible tool. Start by examining the color of the mushroom, as it can vary widely and is often a key identifier. Medicinal species like *Reishi* (*Ganoderma lucidum*) typically have a distinct reddish-brown to varnished brown cap, while *Chaga* (*Inonotus obliquus*) appears as a dark, charcoal-like mass. *Turkey Tail* (*Trametes versicolor*) displays bands of brown, tan, and white. Note any color changes when the mushroom is bruised or ages, as this can also be diagnostic. Always compare the observed colors with reliable guides or images, as lighting conditions can affect perception.
Next, assess the shape of the mushroom, particularly the cap and overall structure. Medicinal mushrooms often have unique forms: *Reishi* has a kidney-shaped or fan-like cap, *Lion's Mane* (*Hericium erinaceus*) resembles cascading icicles or a shaggy mane, and *Chaga* forms a lumpy, irregular mass on tree bark. The cap shape can be convex, flat, or even shelf-like in bracket fungi like *Turkey Tail*. Pay attention to the size and proportions, as these can differentiate between similar species. For example, *Reishi* caps are typically 8–20 cm wide, while *Lion's Mane* can grow much larger.
The gills or underside of the cap are crucial for identification. Some medicinal mushrooms, like *Lion's Mane*, lack gills and instead have tooth-like spines. Others, such as *Maitake* (*Grifola frondosa*), have forked or gill-like structures on the underside of their clustered caps. *Reishi* has thin, closely spaced pores instead of gills. Examine the color, spacing, and attachment of these features, as they can vary significantly between species. For instance, *Turkey Tail* has white pores that release spores, while *Chaga* has a rusty-brown interior when cut open.
Cap texture is another important visual characteristic. Medicinal mushrooms exhibit a range of textures: *Reishi* has a hard, woody cap with a varnished or lacquered appearance, while *Lion's Mane* is soft and shaggy when young, becoming brittle with age. *Chaga* is hard and cracked, resembling burnt wood. *Turkey Tail* has a smooth to slightly velvety cap surface with distinct zonal bands. Texture can also indicate freshness or maturity, which is important for harvesting at the optimal stage for medicinal use.
Finally, examine the stem features if present. Some medicinal mushrooms, like *Reishi*, have a lateral or absent stem, while others, such as *Maitake*, have a central, branched stem supporting multiple caps. The stem's color, thickness, and texture are important: *Reishi* stems are typically brown and tough, while *Lion's Mane* has a small, stubby base. *Turkey Tail* often lacks a distinct stem, growing directly from wood as a bracket fungus. Note any rings, volvas, or other stem structures, though these are less common in medicinal species. Combining these stem observations with other visual characteristics will help narrow down the identification.
Mushroom Cow's Demise: Unveiling the Mystery
You may want to see also

Habitat Analysis: Study soil, climate, and surrounding plants where medicinal mushrooms grow
Understanding the habitat of medicinal mushrooms is crucial for their identification and cultivation. Habitat analysis involves a detailed study of the soil, climate, and surrounding plants where these fungi thrive. Medicinal mushrooms often have specific environmental requirements, and recognizing these can significantly aid in locating and identifying their colonies. Here’s how to approach this analysis:
Soil Composition and Quality: Medicinal mushrooms typically grow in nutrient-rich, well-drained soils. The pH level of the soil is a critical factor; most medicinal mushrooms prefer slightly acidic to neutral pH ranges. For instance, Reishi mushrooms (*Ganoderma lucidum*) often grow on decaying hardwood logs in forests with loamy soil. Conducting a soil test can reveal essential nutrients like nitrogen, phosphorus, and potassium, which are vital for fungal growth. Mycorrhizal mushrooms, such as Chaga (*Inonotus obliquus*), form symbiotic relationships with tree roots, so examining root systems and soil around specific tree species can be particularly insightful.
Climate Conditions: Climate plays a pivotal role in the growth and distribution of medicinal mushrooms. Factors such as temperature, humidity, and rainfall patterns are essential. For example, Lion's Mane (*Hericium erinaceus*) thrives in cooler, temperate climates with high humidity. Monitoring local weather patterns and microclimates within forests can help identify areas where these mushrooms are likely to grow. Seasonal changes also influence mushroom growth; many medicinal species fruit in the fall when temperatures drop and humidity rises.
Surrounding Flora: The presence of specific plants and trees can be a strong indicator of medicinal mushroom habitats. Many mushrooms form symbiotic relationships with certain tree species. For instance, Birch trees are commonly associated with Chaga, while Oak and Maple trees often host Turkey Tail (*Trametes versicolor*). Observing the understory vegetation can also provide clues; some mushrooms prefer shaded areas with a dense layer of moss and ferns, which retain moisture and create a suitable microclimate.
Geographical Location and Elevation: Different medicinal mushrooms are adapted to specific geographical regions and elevations. For example, Cordyceps (*Ophiocordyceps sinensis*) is predominantly found in the high-altitude regions of the Himalayas. Mapping the distribution of known medicinal mushroom species can help identify potential habitats in similar environments. Elevation affects temperature and atmospheric pressure, which in turn influence mushroom growth, so noting the altitude of a location is crucial for habitat analysis.
Microhabitat Features: Beyond the broader environment, microhabitat features can be decisive for mushroom growth. This includes aspects like the presence of decaying wood, leaf litter, or animal burrows. Some mushrooms, like the Oyster mushroom (*Pleurotus ostreatus*), thrive on decaying wood, while others may prefer the unique conditions found near ant or termite nests. Examining these microhabitats can provide valuable insights into the specific needs of different medicinal mushroom species.
By systematically studying these habitat factors, enthusiasts and researchers can more effectively identify and cultivate medicinal mushroom colonies, ensuring a sustainable and reliable source of these valuable fungi.
Mushroom Mystery: Are Outback Mushrooms Keto-Friendly?
You may want to see also

Spore Print Testing: Collect and analyze spore colors to differentiate species accurately
Spore print testing is a crucial technique for accurately identifying mushroom species, especially when distinguishing medicinal varieties. This method involves collecting and analyzing the spores released by the mushroom’s gills, pores, or teeth, which often reveal distinct colors that serve as a key identifier. To begin, select a mature mushroom specimen with fully developed gills or pores. Place the cap of the mushroom on a piece of white or black paper (or glass for transparency), depending on the expected spore color, and cover it with a bowl to create a contained environment. Allow the mushroom to sit undisturbed for several hours, typically overnight, to ensure all spores are released. The resulting spore deposit, known as the spore print, will display a color that can be compared against known species profiles.
The process of collecting a spore print requires precision and patience. Ensure the mushroom cap is positioned correctly, with the fertile surface (gills, pores, or teeth) facing downward, to allow spores to fall naturally. The choice of paper color is important for visibility; light-colored spores show up better on dark paper, while dark spores are more visible on light paper. After the collection period, carefully remove the bowl and cap, leaving the spore print intact. Observe the color of the spore deposit, noting its hue, saturation, and any variations. Common spore colors include white, cream, brown, black, purple, or even reddish tones, each narrowing down the possible species.
Analyzing the spore print color is a direct and reliable way to differentiate mushroom species. For example, *Reishi* (*Ganoderma lucidum*) produces a brown spore print, while *Lion’s Mane* (*Hericium erinaceus*) has a white to yellowish print. Medicinal mushrooms often have specific spore colors that align with their taxonomic classification. Cross-reference the observed color with field guides, online databases, or mycological resources to match it to known species. This step is critical, as spore color is one of the most consistent and definitive characteristics for identification.
While spore print testing is highly effective, it should be used in conjunction with other identification methods for accuracy. Factors such as environmental conditions, mushroom age, or contamination can affect spore color, so consistency in technique is key. Additionally, some species may have subtle color variations, requiring further examination of physical features like cap shape, stem texture, or habitat. For medicinal mushrooms, precise identification is essential to ensure safety and efficacy, as misidentification can lead to toxic or ineffective species being harvested.
In summary, spore print testing is an indispensable tool for identifying medicinal mushroom colonies. By carefully collecting and analyzing spore colors, enthusiasts and researchers can accurately differentiate species, ensuring the correct medicinal varieties are selected. This method, combined with other identification techniques, provides a robust framework for safe and effective mushroom foraging and cultivation. Always approach mushroom identification with caution and consult expert resources when in doubt.
Mushrooms: Living Organisms or Not?
You may want to see also
Explore related products
$6.97 $18.95

Smell and Taste: Note unique aromas and flavors associated with medicinal varieties
When identifying medicinal mushroom colonies, paying close attention to smell and taste can provide crucial clues. Medicinal mushrooms often possess distinct aromatic profiles that set them apart from their non-medicinal counterparts. For instance, Reishi (Ganoderma lucidum) is known for its earthy, woody, and slightly bitter scent, often described as reminiscent of old wood or varnish. This unique aroma is a key identifier, as it contrasts sharply with the milder or more pungent smells of other fungi. Similarly, Chaga (Inonotus obliquus) has a mild, earthy odor with subtle hints of vanilla, which becomes more pronounced when the mushroom is dried or brewed into tea. Familiarizing yourself with these characteristic scents can significantly aid in accurate identification.
Taste is another important sensory aspect to consider when evaluating medicinal mushrooms. Lion's Mane (Hericium erinaceus) is notable for its mild, seafood-like flavor, often compared to crab or lobster, which makes it a unique culinary and medicinal mushroom. In contrast, Turkey Tail (Trametes versicolor) has a very bland or slightly bitter taste, which is less about flavor and more about its medicinal properties. Shiitake (Lentinula edodes) offers a rich, umami taste with a meaty texture, but its medicinal varieties often have a more pronounced earthy undertone. It’s essential to note that while taste can be subjective, consistent descriptions across reliable sources can help confirm the identity of a medicinal mushroom.
Some medicinal mushrooms have aromas and flavors that change with preparation. For example, Cordyceps (Ophiocordyceps sinensis) has a slightly sweet and earthy smell when raw, but when cooked or brewed, it develops a more robust, almost nutty flavor. This transformation can be a useful indicator of its authenticity. Similarly, Maitake (Grifola frondosa) has a rich, earthy aroma with hints of spices, and its taste becomes more pronounced when sautéed or simmered, revealing a deep, savory profile. Observing how these sensory qualities evolve during preparation can further validate your identification.
It’s important to approach tasting wild mushrooms with caution, as some toxic species can resemble medicinal varieties. Always cross-reference smell and taste observations with other identification methods, such as spore prints, gill structure, and habitat. For instance, while Poria (Wolfiporia cocos) has a bland, slightly sweet taste and a faint woody aroma, it closely resembles other fungi that are inedible or harmful. When in doubt, consult expert guides or mycologists to ensure safe and accurate identification.
Lastly, documenting your sensory observations systematically can enhance your identification skills. Note the intensity, complexity, and persistence of aromas and flavors. For example, Agarikon (Fomitopsis officinalis) has a strong, resinous smell with a bitter taste that lingers, which is distinct from other shelf fungi. Creating a sensory profile for each medicinal mushroom you encounter will not only aid in identification but also deepen your understanding of their unique characteristics. This meticulous approach ensures that you can confidently distinguish medicinal colonies from other fungi in the wild.
Mushroom Bags: Filter or No Filter?
You may want to see also

Microscopic Examination: Use microscopy to identify cellular structures and confirm species
Microscopic examination is a critical step in accurately identifying medicinal mushroom species, as it allows for the detailed observation of cellular structures that are often unique to each species. To begin, prepare a spore print or tissue sample from the mushroom colony. Place a small piece of the mushroom’s gill, cap, or stem on a glass slide, and cover it with a drop of distilled water or a mounting medium like glycerin. Gently place a cover slip over the sample, ensuring no air bubbles remain, as they can obstruct clear viewing. This preparation ensures the cellular structures are visible under a microscope.
Once the sample is prepared, use a compound light microscope with a magnification of at least 400x to examine the spores, cystidia, and other cellular features. Start by identifying the spore shape, size, and color, as these characteristics are highly species-specific. For example, *Reishi* (*Ganoderma lucidum*) spores are double-walled and elliptical, while *Chaga* (*Inonotus obliquus*) spores are black and elongated. Additionally, observe the presence of cystidia, which are specialized cells found on the gills or pores of mushrooms. Their shape, size, and distribution can further narrow down the species.
Another key aspect of microscopic examination is analyzing the hyphae, the thread-like structures that make up the mushroom’s body. Some medicinal mushrooms, like *Lion’s Mane* (*Hericium erinaceus*), have unique hyphae with clamp connections, which are small bridges between cells. Others may exhibit septate or non-septate hyphae, depending on the species. Examining the hyphal system can provide crucial clues about the mushroom’s identity and its potential medicinal properties.
For more advanced identification, consider staining techniques to highlight specific cellular components. Methylene blue or cotton blue stains can be used to differentiate between living and dead cells, while Melzer’s reagent can test for amyloid or dextrinoid reactions in spores and cystidia. These reactions, where the structures change color in response to the reagent, are diagnostic for certain species. For instance, amyloid spores turn blue-black with Melzer’s reagent, a characteristic of some *Psilocybe* species, though not typically medicinal.
Finally, compare your microscopic observations with reliable mycological references or databases, such as *Agaricus* or *The Audubon Society Field Guide to North American Mushrooms*. These resources provide detailed descriptions of cellular structures for various species, enabling you to confirm your identification. Microscopic examination, when combined with macroscopic features and habitat analysis, ensures accurate species identification, which is essential for safely utilizing medicinal mushroom colonies.
How to Revive Mushrooms with Replenish
You may want to see also
Frequently asked questions
Look for specific characteristics such as color, texture, and habitat. Medicinal mushrooms like Reishi, Chaga, and Lion's Mane often have distinct appearances. Reishi has a shiny, kidney-shaped cap, Chaga appears as black, charcoal-like growths on birch trees, and Lion's Mane has cascading, icicle-like spines. Always consult a field guide or expert for accurate identification.
Key features include the mushroom's cap shape, color, gills or pores, stem structure, and habitat. For example, Turkey Tail mushrooms have fan-shaped caps with banded colors and grow on decaying wood. Additionally, note the smell and any unique characteristics, such as the spongy texture of Chaga.
Yes, use field guides, mobile apps like iNaturalist or Mushroom Observer, and local mycological clubs for assistance. A magnifying glass, knife, and spore print kit can also aid in detailed examination. Always cross-reference findings with multiple sources to avoid misidentification.











































